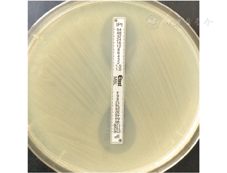
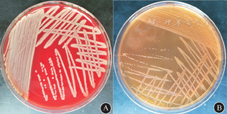

探讨一株香味类香味菌碳青霉烯类药物的耐药基因及治疗方案。
菌株分离自2013年5月上海交通大学医学院附属新华医院一例尿路感染患者的右肾造瘘引流液样本。采用MicroflexTM MALDI–TOF MS和16S rDNA基因测序方法对菌株进行鉴定,用Vitek 2 Compact全自动微生物分析仪联合浓度梯度(E–test)法进行药敏试验,改良Hodge试验及亚胺培南/亚胺培南–金属酶抑制剂(IP/IPI)E–test法进行耐药表型筛查;采用PCR方法检测blaMUS–1、blaVIM–1、blaVIM–2、blaIMP–1、blaIMP–2、blaNDM–1、blaOXA–48和blaGES等碳青霉烯酶基因,并对阳性片段进行基因测序。
该菌株经鉴定为香味类香味菌,它对常规的17种抗菌药物均耐药,其中亚胺培南的最低抑菌浓度(MIC)为≥16 μg/mL;但对米诺环素敏感(MIC为0.38 μg/mL),美罗培南中介(MIC为6 μg/mL)。菌株改良Hodge试验阴性,金属酶抑制试验阳性(IP/IPI>8),PCR产物测序证实该菌株携带有金属β–内酰胺酶MUS–1基因(blaMUS–1)。美罗培南联合米诺环素治疗有效。
该株香味类香味菌携带blaMUS–1基因可能是对碳青霉烯类药物耐药的原因,对该菌的感染,临床上应结合药敏试验制订治疗方案。

版权归中华医学会所有。
未经授权,不得转载、摘编本刊文章,不得使用本刊的版式设计。
除非特别声明,本刊刊出的所有文章不代表中华医学会和本刊编委会的观点。
类香菌属是一类需氧的革兰阴性杆菌,由气味类香菌、香味类香味菌以及最近发现的新种Myroides injenensis组成[1,2],其中香味类香味菌极少在临床样本中分离到,但近几年出现过数例香味类香味菌引起免疫正常宿主严重感染的报道[3,4]。类香菌属多为多重耐药菌株,由于感染类香菌属的患者较少,对耐药机制的研究尚不深入,临床治疗方面经验不够丰富。2013年5月我院临床微生物实验室从一例泌尿外科患者的右肾造瘘引流液中多次分离培养到香味类香味菌,药敏试验结果显示该菌对包括碳青霉烯类在内的多种抗菌药物耐药。本研究初步探讨了菌株对碳青霉烯类药物的耐药机制并结合治疗经验及相关文献报道总结多重耐药类香菌属感染较为合理的治疗方案。
患者女,78岁,因"右肾造瘘术后伴发热1月余"于2013年5月收治上海交通大学医学院附属新华医院泌尿外科。该患者入院前1个月曾在外院行右侧经皮肾镜取石术,术后拔除右肾造瘘管后无法自行排尿,故留置右肾造瘘管离院。之后反复出现发热、右侧腰部疼痛等症状,左氧氟沙星治疗无效。患者入我院后从右肾造瘘引流液多次培养出同一株细菌。将菌株转种于血平板和麦康凯平板,35℃电热恒温培养箱中孵育16~24 h,采用Microflex™ MALDI–TOF MS和细菌16S rDNA基因测序进行鉴定[5]。质控菌株为大肠埃希菌ATCC 25922、铜绿假单胞菌ATCC 27853、肺炎克雷伯菌ATCC 700603由上海市临床检验中心提供。产KPC–2酶肺炎克雷伯菌LYKPC由上海交通大学附属第六人民医院检验科惠赠。产IMP–1、VIM–2酶铜绿假单胞菌(RJIMP–1、RJVIM–2)由上海交通大学医学院附属瑞金医院微生物科惠赠。
麦康凯平板、血平板和MH平板购自上海伊华生物技术有限公司,电热恒温培养箱购自上海恒一科学仪器有限公司,Microflex™ MALDI–TOF MS购自德国Bruker Daltonik公司,Vitek 2 Compact全自动微生物分析系统、药敏鉴定卡(GN13)、米诺环素E–test试纸条、美罗培南E–test试纸条和亚胺培南/亚胺培南–金属酶抑制剂(IP/IPI) E–test试纸条购自法国Bio Mérieux公司,PCR仪购自德国Eppendorf公司,凝胶成像系统购自Tanon公司,PCR扩增试剂盒、DNA凝胶回收试剂盒均购自上海生工生物工程有限公司,DNA测序仪及基因测序试剂盒购自美国Applied Biosystems公司,水平电泳仪购自美国Bio–Rad公司。
挑取平板上纯菌落,按Vitek 2 Compact全自动微生物分析药敏系统操作规程进行药敏试验,美罗培南和米诺环素的最低抑菌浓度(MIC)由E–test纸条法测定。按照2012版美国临床和实验室标准化协会(CLSI)标准对药敏试验结果进行判读[6]。
将大肠埃希菌ATCC 25922配置为0.5麦氏浊度,稀释10倍后均匀涂布于MH平板,平板中央贴美罗培南纸片(10 μg)。接种环挑取新鲜培养待测菌的单菌落以纸片边缘为起点离心方向划线接种。36℃空气培养16~24 h后观察结果。肺炎克雷伯菌ATCC 700603为阴性对照株,肺炎克雷伯菌LYKPC作为阳性对照株。若待测菌划线与ATCC 25922抑菌圈边缘交叉部分呈箭头状则为阳性。
采用IP/IPI E–test试验,取新鲜培养的待测菌配置为0.5麦氏浊度,均匀涂布于MH平板,将IP/IPI E–test纸条贴于平板中央。置于36℃空气培养16~24 h,读取抑菌圈与纸条边缘交界处的数值。若IP侧数值与IPI侧数值之比大于8则表明待测菌株产金属酶。
煮沸法提取细菌总DNA。根据美国国立生物技术信息中心(NCBI)上MUS–1全基因序列设计特异性引物(F: GGTCA TCACTACCCACTTCCAC, R: AAGCTATCACGTTAC CATCGGC,323 bp)、blaIMP–1、blaIMP–2、blaVIM–1、blaVIM–2和blaNDM–1金属β–内酰胺酶基因,以及blaOXA–48和blaGES等其他类型碳青霉烯酶基因,引物序列及反应条件见参考文献[8,9]。PCR扩增产物进行琼脂糖凝胶电泳,参数为120 V,40 min。电泳结束后将琼脂糖凝胶置于紫外凝胶成像仪中观察结果并摄片。
PCR扩增目的基因,按照DNA凝胶回收试剂盒的操作步骤回收琼脂糖凝胶中的目的条带,以回收的DNA作为模板进行单向PCR(反应体系及扩增程序参照BigDye Terminator v3.1测序试剂盒的操作手册)。采用ABI PRISM 310 Genetic Analyzer测序仪对纯化后的单向PCR反应产物进行测序。测序结果提交NCBI网站进行比对。
菌株在35℃有氧条件下孵育24 h后,血平板上出现浅黄色,中等大小菌落,具有特殊的芳香气味。在麦康凯平板上孵育24 h后出现细小,黄色半透明菌落(图1)。Microflex™ MALDI–TOF MS和细菌16 SrDNA基因测序等方法均鉴定为香味类香味菌。


注:A.血平板;B.麦康凯平板
培养出的香味类香味菌对17种常规抗菌药物均耐药,其中亚胺培南的MIC值为≥16 μg/mL,E–test方法显示美罗培南和米诺环素对该菌株的MIC分别为6 μg/mL和0.38 μg/mL,判读为中介和敏感(表1)。

| 抗菌药物 | 最低抑菌浓度(μg/mL) | 判读结果 |
|---|---|---|
| 头孢唑啉 | ≥64 | 耐药 |
| 环丙沙星 | ≥4 | 耐药 |
| 呋喃妥因 | 256 | 耐药 |
| 头孢替坦 | ≥64 | 耐药 |
| 氨苄西林/舒巴坦 | ≥32 | 耐药 |
| 亚胺培南 | ≥16 | 耐药 |
| 头孢曲松 | ≥64 | 耐药 |
| 头孢吡肟 | ≥64 | 耐药 |
| 氨苄西林 | ≥32 | 耐药 |
| 庆大霉素 | ≥16 | 耐药 |
| 复方磺胺甲噁唑 | ≥320 | 耐药 |
| 妥布霉素 | ≥16 | 耐药 |
| 左氧氟沙星 | ≥8 | 耐药 |
| 头孢他啶 | ≥64 | 耐药 |
| 哌拉西林/他唑巴坦 | ≥128 | 耐药 |
| 阿米卡星 | ≥64 | 耐药 |
| 氨曲南 | ≥64 | 耐药 |
| 美罗培南 | 6 | 中介 |
| 米诺环素 | 0.38 | 敏感 |
改良Hodge试验呈阴性。IP/IPI﹥8,金属酶抑制试验阳性(图2),提示该菌株可能产金属β–内酰胺酶。


注:亚胺培南/亚胺培南–金属酶抑制剂(IP/IPI)﹥8
PCR方法扩增碳青霉烯酶基因后,发现在323 bp处存在一明显条带,为blaMUS–1基因(图3),对该基因片段进行测序,并在NCBI上比对,证实该菌株确实携带有blaMUS–1基因(图4)。blaVIM–1、blaVIM–2、blaIMP–1、blaIMP–2、blaNDM–1、blaOXA–48和blaGES等基因均为阴性。


注:M.标准带;N.阴性对照;IMP–1、VIM–2阳性条带.铜绿假单胞菌RJIMP–1,RJVIM–2阳性对照;MUS–1~GES.香味类香味菌碳青霉烯酶基因


患者经验性使用左氧氟沙星(0.5 g,1次/d)治疗,症状无明显缓解。改用磷霉素(4 g,2次/d)联合氨曲南(1 g,1次/8 h)静脉滴注抗感染治疗。患者仍有发热、右侧腰部疼痛,且多次引流液培养结果仍为香味类香味菌生长。后经专家会诊及药敏试验改为米诺环素(100 mg,2次/d,口服)联合美罗培南(0.5 g,1次/12 h,静脉滴注)治疗。一周后患者体温恢复正常,右侧腰部疼痛明显缓解,之后右肾造瘘引流液3次培养均无细菌生长,后行右输尿管镜取石术,手术顺利,术后痊愈出院。
类香菌属是一种寄居环境特定的细菌,常从潮湿的环境、泥土、昆虫肠道、海水中分离出来,同时作为很多混合菌株生物膜的组成部分。类香菌属可引起免疫缺陷患者的尿路感染、蜂窝织炎、败血症、肺炎、脑膜炎、筋膜炎及静脉炎等[3],临床报道较少,而香味类香味菌感染病例更为罕见。类香菌属本身有很强的黏附能力,对免疫正常的宿主亦具有一定的侵袭能力[10,11],但目前其感染源尚不明确,可能来自泥土、水源、导管和昆虫等等。本例患者生活在农村,可能接触了含有类香菌属细菌的泥土、水源等,且该患者长时间留置右肾造瘘管,根据Spanik等[12]之前的报道,导管可以作为类香菌属感染的一个独立危险因素,因此推测该患者的肾造瘘管也可能是一个促成此菌感染的媒介。最近有报道在食肉蝇的胃肠道中分离出多重耐药的类香菌属[13],该患者发病时间为5月,正值夏季,食肉蝇等活动较频繁,可能是引起感染的原因之一。因此,避免开放性伤口与土壤、水源、昆虫的接触,加强对导管置入患者的规范化护理可以预防香味类香味菌感染的发生。
本研究中的感染病例来自我院泌尿外科,该患者右肾造瘘引流液多次培养出香味类香味菌。该分离株对β–内酰胺类(包括氨曲南、碳青霉烯类)、喹诺酮类、氨基糖苷类以及磺胺类均耐药。根据既往文献报道,多重耐药香味类香味菌对多黏菌素、利福平、米诺环素等仍保持敏感,而且即使体外药敏试验提示临床分离株对碳青霉烯类抗生素耐药,在联合治疗方案中加入亚胺培南复方制剂(亚胺培南–西司他丁)或美罗培南仍可取得满意的疗效[14,15]。故本微生物室后续采用E–test方法进行补充药敏试验,发现其对美罗培南中介,对米诺环素敏感。由于患者入院时查腹部CT提示左肾皮质萎缩,左肾功能丧失,考虑到米诺环素有一定的肾毒性,故予米诺环素常规剂量减半口服联合美罗培南静脉滴注,1周后患者体温恢复正常,之后连续3次尿培养均为阴性。从患者的预后来看,这两种药物的治疗效果明显。Mammeri等[16]研究发现类香菌属菌株对包括氨曲南和碳青霉烯类在内的β–内酰胺类耐药可能与其产生染色体介导、锌离子依赖的金属β–内酰胺酶MUS–1水解碳青霉烯类及其他β–内酰胺类抗生素有关。本研究中菌株的金属酶抑制试验阳性,提示该菌株可产生金属酶,通过PCR及测序等方法证实该菌株携带有blaMUS–1基因,因此该菌株对于碳青霉烯类耐药的机制可能是由于产blaMUS–1基因编码的金属β–内酰胺酶所致。结合实验结果及病例特点,推测MUS–1金属酶可能对亚胺培南的水解能力较强,但对美罗培南的水解能力较弱。因此在敏感抗生素选择有限的情况下,尤其当致病菌株耐药性是由于携带blaMUS–1基因所致时,我们将美罗培南列入抗生素联合治疗方案的选项之一。需要指出的是,由于香味类香味菌耐药性的相关资料较少,临床微生物室对此类细菌进行药敏试验所选择的抗生素种类可能并不全面,当药敏结果提示为泛耐药时,临床医师应有针对性地加做其他抗菌药物药敏试验,如米诺环素、美罗培南等,再根据患者的具体情况制订合理的治疗方案。
Bachmeyer等[14]报道了从昆虫肠道分离出的不携带blaMUS–1基因的香味类香味菌,该菌株的耐药谱与临床分离株相似,而且,在拮抗效应试验中发现该菌株可以抑制多种细菌的生长,推测该菌属可能还存在其他外分泌机制导致其耐药。也有报道称类香菌属对阿米卡星、庆大霉素、卡那霉素的耐药可能与质粒介导有关,而对于其他抗生素耐药则与染色体介导有关[17]。该菌株其他类型的耐药机制如是否存在膜孔蛋白缺失、外排泵基因过表达等需进一步研究证实。